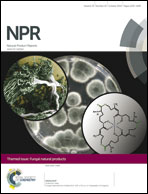

Fungal polyketide biosynthesis – a personal perspective†
Abstract
This Viewpoint article provides a personal viewpoint of research in the area of fungal polyketide biosynthesis. It spans the period from the first applications and subsequent development of modern stable-isotope labelling methods, the isolation, sequencing and expression of PKS genes, biochemical and structural characterisation of PKS domains, fungal genome sequencing, through to genetic engineering of whole pathways. This article forms part of a “trilogy” of related Viewpoints from three close contemporaries who have been privileged to share in these developments since their outset over forty years ago and to enjoy both professional and personal interactions throughout that time.

- This article is part of the themed collections: Celebrating our 2018 prize and award winners and Fungal Natural Products
Please wait while we load your content...
Please wait while we load your content...